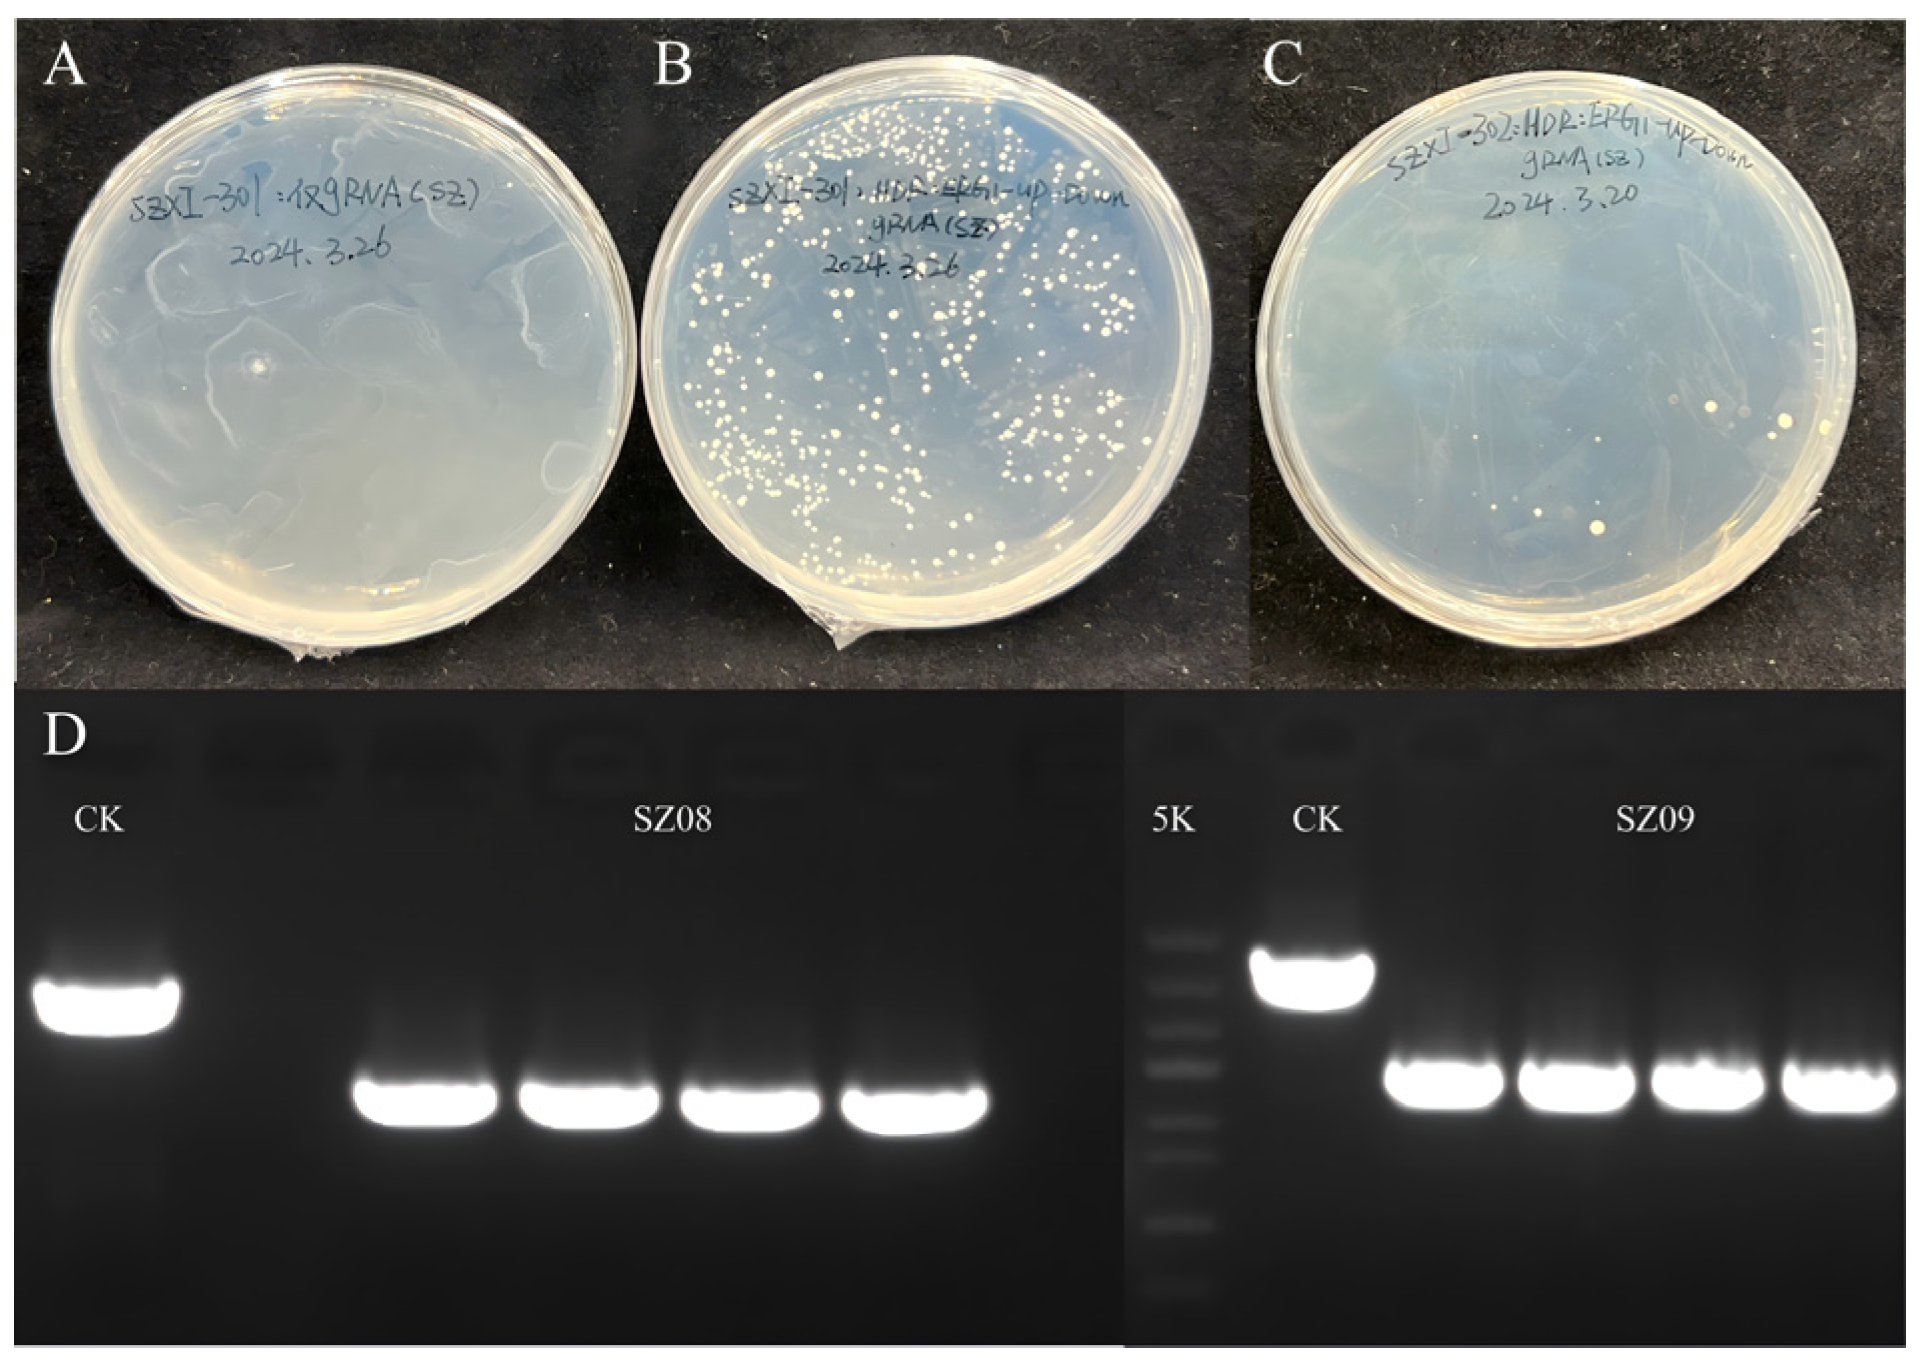
Plants 14 01740 g005
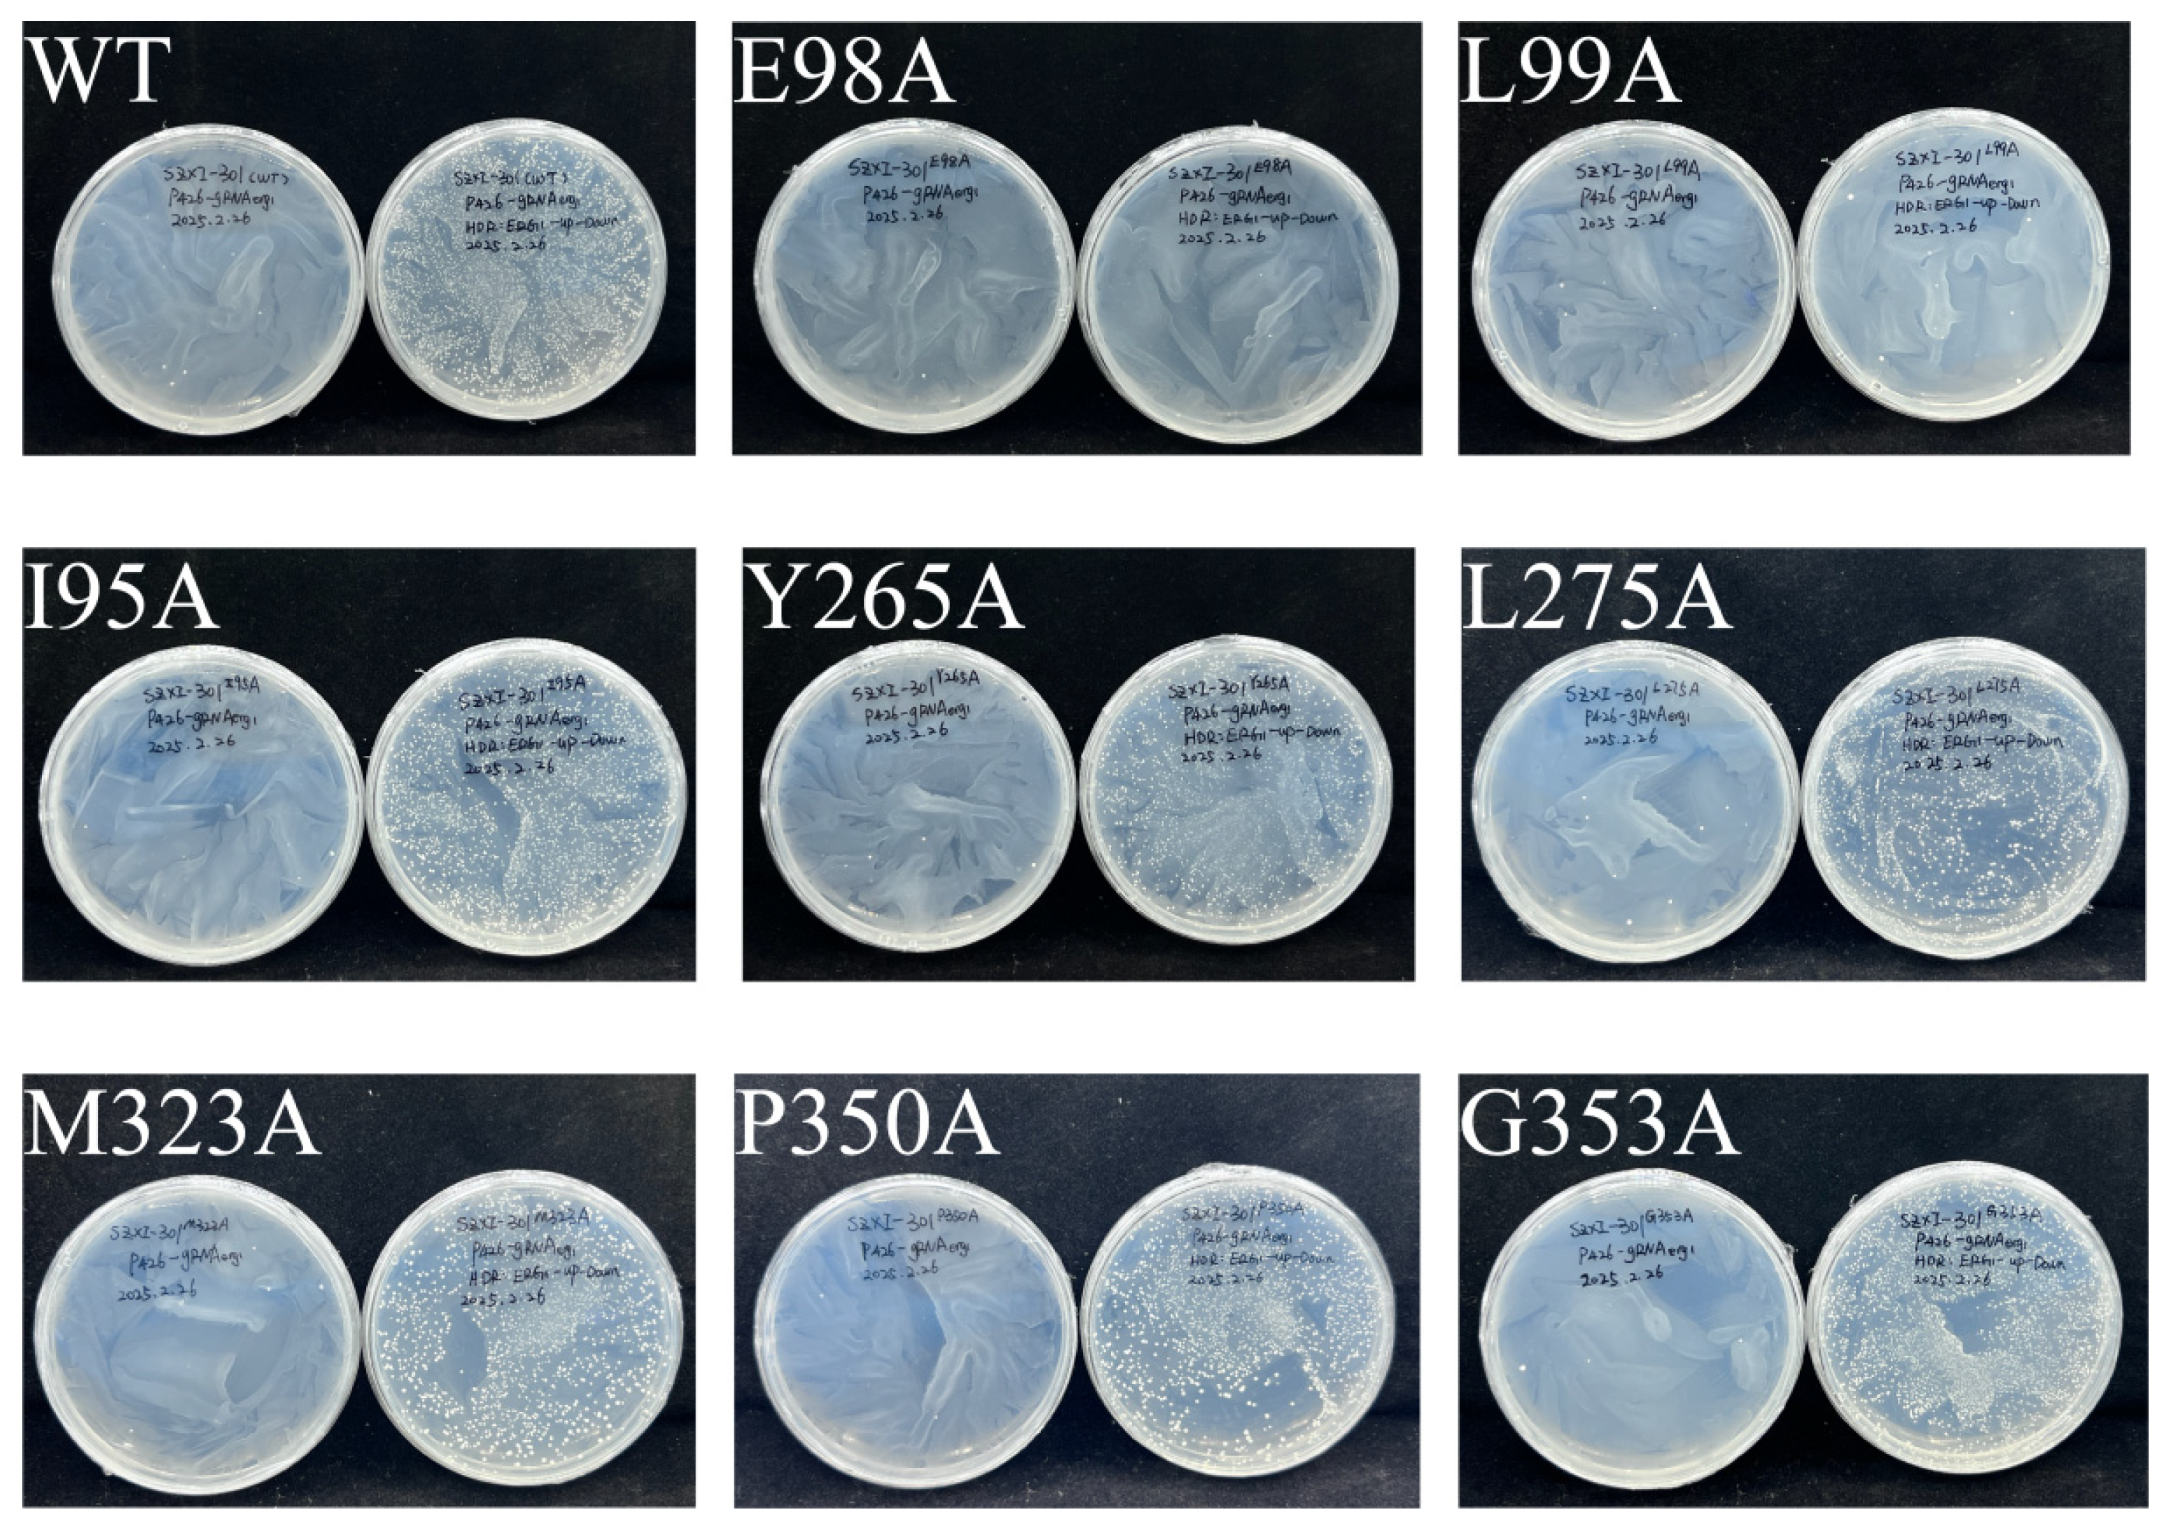
Plants 14 01740 g012

Functional Characterization of Squalene Epoxidases from Siraitia grosvenorii
Abstract
1. Introduction
2. Results
2.1. Cloning and Sequence Analysis of SQEs in S. grosvenorii
2.2. Functional Identification in ∆erg1 Saccharomyces cerevisiae
2.3. Subcellular Localization Analysis of SgSQEs
2.4. Expression Patterns of SgSQE1 and SgSQE2 in S. grosvenorii
2.5. Molecular Docking Analysis and Determination of Key Residues of SgSQE
3. Discussion
4. Conclusions
5. Materials and Methods
5.1. Plant Materials and Plasmids
5.2. Gene Cloning and Gene Synthesis
5.3. Bioinformatic Analysis of SgSQEs
5.4. Functional Characterization of SgSQEs in S. cerevisiae
5.4.1. Heterologous Expression of the SgSQE Gene in S. cerevisiae
5.4.2. Knockout of erg1
5.4.3. Construction of SQE Expression Vectors
5.4.4. Replacement of ERG7 Promoter with Weak Promoter pHXT1
5.4.5. Yeast Fermentation and Product Detection Using GC-MS
5.5. Subcellular Localization
5.6. Expression Patterns of SgSQEs in Different Organs and Different Growth Periods of Fruits
5.7. Molecular Docking Analysis and Site-Directed Mutagenesis
Supplementary Materials
Author Contributions
Funding
Data Availability Statement
Conflicts of Interest
References
- Tan, Y.R.; Shen, S.Y.; Li, X.Y.; Yi, P.F.; Fu, B.D.; Peng, L.Y. Mogroside V reduced the excessive endoplasmic reticulum stress and mitigated the Ulcerative colitis induced by dextran sulfate sodium in mice. J. Transl. Med. 2024, 22, 488. [Google Scholar] [CrossRef] [PubMed]
- Chen, M.; Li, L.; Qin, Y.; Teng, H.; Lu, C.; Mai, R.; Zhu, Z.; Mo, J.; Qi, Z. Mogroside V ameliorates astrocyte inflammation induced by cerebral ischemia through suppressing TLR4/TRADD pathway. Int. Immunopharmacol. 2025, 148, 114085. [Google Scholar] [CrossRef] [PubMed]
- Li, Y.; Shen, D.; Wang, K.; Xue, Y.; Liu, J.; Li, S.; Li, X.; Li, C. Mogroside V ameliorates broiler pulmonary inflammation via modulating lung microbiota and rectifying Th17/Treg dysregulation in lipopolysaccharides-induced lung injury. Poult. Sci. 2023, 102, 103138. [Google Scholar] [CrossRef] [PubMed]
- Takasaki, M.; Konoshima, T.; Murata, Y.; Sugiura, M.; Nishino, H.; Tokuda, H.; Matsumoto, K.; Kasai, R.; Yamasaki, K. Anticarcinogenic activity of natural sweeteners, cucurbitane glycosides, from Momordica grosvenori. Cancer Lett. 2003, 198, 37–42. [Google Scholar] [CrossRef]
- Shi, J.L.; Sun, T.; Li, Q.; Li, C.M.; Jin, J.F.; Zhang, C. Mogroside V protects against acetaminophen-induced liver injury by reducing reactive oxygen species and c-jun-N-terminal kinase activation in mice. World J. Hepatol. 2025, 17, 104520. [Google Scholar] [CrossRef]
- Liu, Y.; Wang, J.; Dou, T.; Zhou, L.; Guan, X.; Liu, G.; Li, X.; Han, M.; Chen, X. The liver metabolic features of Mogroside V compared to Siraitia grosvenorii fruit extract in allergic pneumonia mice. Mol. Immunol. 2022, 145, 80–87. [Google Scholar] [CrossRef]
- Liu, H.; Qi, X.; Yu, K.; Lu, A.; Lin, K.; Zhu, J.; Zhang, M.; Sun, Z. AMPK activation is involved in hypoglycemic and hypolipidemic activities of mogroside-rich extract from Siraitia grosvenorii (Swingle) fruits on high-fat diet/streptozotocin-induced diabetic mice. Food Funct. 2019, 10, 151–162. [Google Scholar] [CrossRef]
- Wu, Y.; Yao, Y.; Shen, Y.; Bai, H.; Zhang, L.; Zhang, C. Nanoplastics Chronic Toxicity in Mice: Disturbing the Homeostasis of Tryptophan Metabolism in Gut-Lung-Microbiota Axis. Small 2025, e2412286. [Google Scholar] [CrossRef]
- Xiao, J.; Huang, K.; Lin, H.; Xia, Z.; Zhang, J.; Li, D.; Jin, J. Mogroside II(E) Inhibits Digestive Enzymes via Suppression of Interleukin 9/Interleukin 9 Receptor Signalling in Acute Pancreatitis. Front. Pharmacol. 2020, 11, 859. [Google Scholar] [CrossRef]
- Jia, X.; Liu, J.; Shi, B.; Liang, Q.; Gao, J.; Feng, G.; Chang, Z.; Li, Q.; Zhang, X.; Chen, J.; et al. Screening Bioactive Compounds of Siraitia grosvenorii by Immobilized β(2)-Adrenergic Receptor Chromatography and Druggability Evaluation. Front. Pharmacol. 2019, 10, 915. [Google Scholar] [CrossRef]
- Zhang, Y.; Peng, Y.; Zhao, L.; Zhou, G.; Li, X. Regulating the gut microbiota and SCFAs in the faeces of T2DM rats should be one of antidiabetic mechanisms of mogrosides in the fruits of Siraitia grosvenorii. J. Ethnopharmacol. 2021, 274, 114033. [Google Scholar] [CrossRef] [PubMed]
- Qin, T.; Li, Y.; Wu, Y.; Meng, F.; Lin, G.; Xia, X. Mogroside Alleviates Diabetes Mellitus and Modulates Intestinal Microflora in Type 2 Diabetic Mice. Biol. Pharm. Bull. 2024, 47, 1043–1053. [Google Scholar] [CrossRef] [PubMed]
- Tang, Q.; Ma, X.; Mo, C.; Wilson, I.W.; Song, C.; Zhao, H.; Yang, Y.; Fu, W.; Qiu, D. An efficient approach to finding Siraitia grosvenorii triterpene biosynthetic genes by RNA-seq and digital gene expression analysis. BMC Genom. 2011, 12, 343. [Google Scholar] [CrossRef] [PubMed]
- Chen, N.; Cao, W.; Yuan, Y.; Wang, Y.; Zhang, X.; Chen, Y.; Yiasmin, M.N.; Tristanto, N.A.; Hua, X. Recent advancements in mogrosides: A review on biological activities, synthetic biology, and applications in the food industry. Food Chem. 2024, 449, 139277. [Google Scholar] [CrossRef]
- Liao, J.; Liu, T.; Xie, L.; Mo, C.; Qiao, J.; Huang, X.; Cui, S.; Jia, X.; Luo, Z.; Ma, X. Heterologous mogrosides biosynthesis in cucumber and tomato by genetic manipulation. Commun. Biol. 2023, 6, 191. [Google Scholar] [CrossRef]
- Zhang, J.; Dai, L.; Yang, J.; Liu, C.; Men, Y.; Zeng, Y.; Cai, Y.; Zhu, Y.; Sun, Y. Oxidation of Cucurbitadienol Catalyzed by CYP87D18 in the Biosynthesis of Mogrosides from Siraitia grosvenorii. Plant Cell Physiol. 2016, 57, 1000–1007. [Google Scholar] [CrossRef]
- Zhou, Y.; Ma, Y.; Zeng, J.; Duan, L.; Xue, X.; Wang, H.; Lin, T.; Liu, Z.; Zeng, K.; Zhong, Y.; et al. Convergence and divergence of bitterness biosynthesis and regulation in Cucurbitaceae. Nat. Plants 2016, 2, 16183. [Google Scholar] [CrossRef]
- Seki, H.; Sawai, S.; Ohyama, K.; Mizutani, M.; Ohnishi, T.; Sudo, H.; Fukushima, E.O.; Akashi, T.; Aoki, T.; Saito, K.; et al. Triterpene functional genomics in licorice for identification of CYP72A154 involved in the biosynthesis of glycyrrhizin. Plant Cell 2011, 23, 4112–4123. [Google Scholar] [CrossRef]
- Dai, L.; Liu, C.; Zhu, Y.; Zhang, J.; Men, Y.; Zeng, Y.; Sun, Y. Functional Characterization of Cucurbitadienol Synthase and Triterpene Glycosyltransferase Involved in Biosynthesis of Mogrosides from Siraitia grosvenorii. Plant Cell Physiol. 2015, 56, 1172–1182. [Google Scholar] [CrossRef]
- Itkin, M.; Davidovich-Rikanati, R.; Cohen, S.; Portnoy, V.; Doron-Faigenboim, A.; Oren, E.; Freilich, S.; Tzuri, G.; Baranes, N.; Shen, S.; et al. The biosynthetic pathway of the nonsugar, high-intensity sweetener mogroside V from Siraitia grosvenorii. Proc. Natl. Acad. Sci. USA 2016, 113, E7619–E7628. [Google Scholar] [CrossRef]
- Zhao, H.; Tang, Q.; Mo, C.; Bai, L.; Tu, D.; Ma, X. Cloning and characterization of squalene synthase and cycloartenol synthase from Siraitia grosvenorii. Acta Pharm. Sin. B 2017, 7, 215–222. [Google Scholar] [CrossRef] [PubMed]
- Zhao, H.; Wang, J.; Tang, Q.; Mo, C.; Guo, J.; Chen, T.; Lin, H.; Tang, J.; Guo, L.; Huang, L.; et al. Functional expression of two NADPH-cytochrome P450 reductases from Siraitia grosvenorii. Int. J. Biol. Macromol. 2018, 120 Pt B, 1515–1524. [Google Scholar] [CrossRef] [PubMed]
- Cui, S.; Zhang, S.; Wang, N.; Su, X.; Luo, Z.; Ma, X.; Li, M. Structural insights into the catalytic selectivity of glycosyltransferase SgUGT94-289-3 towards mogrosides. Nat. Commun. 2024, 15, 6423. [Google Scholar] [CrossRef]
- Almeida, A.; Dong, L.; Khakimov, B.; Bassard, J.E.; Moses, T.; Lota, F.; Goossens, A.; Appendino, G.; Bak, S. A Single Oxidosqualene Cyclase Produces the Seco-Triterpenoid α-Onocerin. Plant Physiol. 2018, 176, 1469–1484. [Google Scholar] [CrossRef]
- Li, J.; Wang, S.; Miao, Y.; Wan, Y.; Li, C.; Wang, Y. Mining and modification of Oryza sativa-derived squalene epoxidase for improved β-amyrin production in Saccharomyces cerevisiae. J. Biotechnol. 2023, 375, 1–11. [Google Scholar] [CrossRef]
- Dym, O.; Eisenberg, D. Sequence-structure analysis of FAD-containing proteins. Protein Sci. 2001, 10, 1712–1728. [Google Scholar] [CrossRef]
- Ødum, M.T.; Teufel, F.; Thumuluri, V.; Almagro Armenteros, J.J.; Johansen, A.R.; Winther, O.; Nielsen, H. DeepLoc 2.1: Multi-label membrane protein type prediction using protein language models. Nucleic Acids Res. 2024, 52, W215–W220. [Google Scholar] [CrossRef]
- Jumper, J.; Evans, R.; Pritzel, A.; Green, T.; Figurnov, M.; Ronneberger, O.; Tunyasuvunakool, K.; Bates, R.; Žídek, A.; Potapenko, A.; et al. Highly accurate protein structure prediction with AlphaFold. Nature 2021, 596, 583–589. [Google Scholar] [CrossRef]
- Ruckenstuhl, C.; Poschenel, A.; Possert, R.; Baral, P.K.; Gruber, K.; Turnowsky, F. Structure-function correlations of two highly conserved motifs in Saccharomyces cerevisiae squalene epoxidase. Antimicrob. Agents Chemother. 2008, 52, 1496–1499. [Google Scholar] [CrossRef]
- Padyana, A.K.; Gross, S.; Jin, L.; Cianchetta, G.; Narayanaswamy, R.; Wang, F.; Wang, R.; Fang, C.; Lv, X.; Biller, S.A.; et al. Structure and inhibition mechanism of the catalytic domain of human squalene epoxidase. Nat. Commun. 2019, 10, 97. [Google Scholar] [CrossRef]
- Cirmena, G.; Franceschelli, P.; Isnaldi, E.; Ferrando, L.; De Mariano, M.; Ballestrero, A.; Zoppoli, G. Squalene epoxidase as a promising metabolic target in cancer treatment. Cancer Lett. 2018, 425, 13–20. [Google Scholar] [CrossRef] [PubMed]
- Laden, B.P.; Tang, Y.; Porter, T.D. Cloning, heterologous expression, and enzymological characterization of human squalene monooxygenase. Arch. Biochem. Biophys. 2000, 374, 381–388. [Google Scholar] [CrossRef] [PubMed]
- Sen, S.E.; Prestwich, G.D. Squalene analogues containing isopropylidene mimics as potential inhibitors of pig liver squalene epoxidase and oxidosqualene cyclase. J. Med. Chem. 1989, 32, 2152–2158. [Google Scholar] [CrossRef] [PubMed]
- Qu, G.; Song, Y.; Xu, X.; Liu, Y.; Li, J.; Du, G.; Liu, L.; Li, Y.; Lv, X. De novo biosynthesis of mogroside V by multiplexed engineered yeasts. Metab. Eng. 2025, 88, 160–171. [Google Scholar] [CrossRef]
- Yin, X.; Zhang, Y.; Wei, W.; Zhao, X.; Xu, S.; Gao, S.; Zhou, J. Overproduction of Cucurbitadienol through Modular Metabolic Engineering and Fermentation Optimization in Saccharomyces cerevisiae. J. Agric. Food Chem. 2025, 73, 718–726. [Google Scholar] [CrossRef]
- Yin, X.; Wei, W.; Chen, Q.; Zhang, Y.; Liu, S.; Gao, S.; Luo, Z.; Zhou, J. Reengineering the Substrate Tunnel to Enhance the Catalytic Efficiency of Squalene Epoxidase. J. Agric. Food Chem. 2024, 72, 24599–24608. [Google Scholar] [CrossRef]
- Jin, K.; Shi, X.; Liu, J.; Yu, W.; Liu, Y.; Li, J.; Du, G.; Lv, X.; Liu, L. Combinatorial metabolic engineering enables the efficient production of ursolic acid and oleanolic acid in Saccharomyces cerevisiae. Bioresour. Technol. 2023, 374, 128819. [Google Scholar] [CrossRef]
- Ruckenstuhl, C.; Lang, S.; Poschenel, A.; Eidenberger, A.; Baral, P.K.; Kohút, P.; Hapala, I.; Gruber, K.; Turnowsky, F. Characterization of squalene epoxidase of Saccharomyces cerevisiae by applying terbinafine-sensitive variants. Antimicrob. Agents Chemother. 2007, 51, 275–284. [Google Scholar] [CrossRef]
- Uchida, H.; Sugiyama, R.; Nakayachi, O.; Takemura, M.; Ohyama, K. Expression of the gene for sterol-biosynthesis enzyme squalene epoxidase in parenchyma cells of the oil plant, Euphorbia tirucalli. Planta 2007, 226, 1109–1115. [Google Scholar] [CrossRef]
- Dong, L.; Pollier, J.; Bassard, J.E.; Ntallas, G.; Almeida, A.; Lazaridi, E.; Khakimov, B.; Arendt, P.; de Oliveira, L.S.; Lota, F.; et al. Co-expression of squalene epoxidases with triterpene cyclases boosts production of triterpenoids in plants and yeast. Metab. Eng. 2018, 49, 1–12. [Google Scholar] [CrossRef]
- Rasbery, J.M.; Shan, H.; LeClair, R.J.; Norman, M.; Matsuda, S.P.; Bartel, B. Arabidopsis thaliana squalene epoxidase 1 is essential for root and seed development. J. Biol. Chem. 2007, 282, 17002–17013. [Google Scholar] [CrossRef] [PubMed]
- Han, J.Y.; Jo, H.-J.; Choi, Y.E. Overexpression of the squalene epoxidase gene (PgSE1) resulted in enhanced production of ginsenosides and phytosterols in transgenic ginseng. Plant Biotechnol. Rep. 2020, 14, 673–682. [Google Scholar] [CrossRef]
- Zhang, Y.; Zeng, Y.; An, Z.; Lian, D.; Xiao, H.; Wang, R.; Zhang, R.; Zhai, F.; Liu, H. Comparative transcriptome analysis and identification of candidate genes involved in cucurbitacin IIa biosynthesis in Hemsleya macrosperma. Plant Physiol. Biochem. 2022, 185, 314–324. [Google Scholar] [CrossRef] [PubMed]
- Chen, G.; Guo, Z.; Shu, Y.; Zhao, Y.; Qiu, L.; Duan, S.; Lin, Y.; He, S.; Li, X.; Feng, X.; et al. Biosynthetic pathway of prescription cucurbitacin IIa and high-level production of key triterpenoid intermediates in engineered yeast and tobacco. Plant Commun. 2024, 5, 100835. [Google Scholar] [CrossRef]
- Rowan, M.G.; Dean, P.D.; Goodwin, T.W. The enzymic conversion of squalene, 2(3),22(23)-diepoxide to alpha-onocerin by a cell-free extract of Ononis spinosa. FEBS Lett. 1971, 12, 229–232. [Google Scholar] [CrossRef]
- Han, J.Y.; In, J.G.; Kwon, Y.S.; Choi, Y.E. Regulation of ginsenoside and phytosterol biosynthesis by RNA interferences of squalene epoxidase gene in Panax ginseng. Phytochemistry 2010, 71, 36–46. [Google Scholar] [CrossRef]
- Zhou, J.; Zhang, Y.; Hu, T.; Su, P.; Zhang, Y.; Liu, Y.; Huang, L.; Gao, W. Functional characterization of squalene epoxidase genes in the medicinal plant Tripterygium wilfordii. Int. J. Biol. Macromol. 2018, 120 Pt A, 203–212. [Google Scholar] [CrossRef]
- Song, W.; Yan, S.; Li, Y.; Feng, S.; Zhang, J.J.; Li, J.R. Functional characterization of squalene epoxidase and NADPH-cytochrome P450 reductase in Dioscorea zingiberensis. Biochem. Biophys. Res. Commun. 2019, 509, 822–827. [Google Scholar] [CrossRef]
- Lin, H.; Wang, J.; Qi, M.; Guo, J.; Rong, Q.; Tang, J.; Wu, Y.; Ma, X.; Huang, L. Molecular cloning and functional characterization of multiple NADPH-cytochrome P450 reductases from Andrographis paniculata. Int. J. Biol. Macromol. 2017, 102, 208–217. [Google Scholar] [CrossRef]
- Brown, A.J.; Chua, N.K.; Yan, N. The shape of human squalene epoxidase expands the arsenal against cancer. Nat. Commun. 2019, 10, 888. [Google Scholar] [CrossRef]
- Kumar, S.; Stecher, G.; Tamura, K. MEGA7: Molecular Evolutionary Genetics Analysis Version 7.0 for Bigger Datasets. Mol. Biol. Evol. 2016, 33, 1870–1874. [Google Scholar] [CrossRef]

| gRNA Name | Sequences (5′-3′) |
|---|---|
| ERG1-target gRNA1 | GGTGAATTGATGCAACCAGG |
| ERG1-target gRNA2 | GGTCAAAGATGGTAATGACA |
| ERG1-target gRNA3 | TACTTGAACATGGAAGAACG |
| ERG1-target gRNA4 | ATGAGACATCCATTGACTGG |
| ERG1-target gRNA5 | TTGGAGAGTTGTAAGCACAA |
| Primers | 5′-3′ Sequences |
|---|---|
| SgSQE1-F | GTTCTATCGCATTAGCAGTA |
| SgSQE1-R | GAGGAGCAACAACATTCT |
| SgSQE2-F | GGTCGCTTATTACTTCCAT |
| SgSQE2-R | GAACATCTGTCTAACTCCTT |
Disclaimer/Publisher’s Note: The statements, opinions and data contained in all publications are solely those of the individual author(s) and contributor(s) and not of MDPI and/or the editor(s). MDPI and/or the editor(s) disclaim responsibility for any injury to people or property resulting from any ideas, methods, instructions or products referred to in the content. |
© 2025 by the authors. Licensee MDPI, Basel, Switzerland. This article is an open access article distributed under the terms and conditions of the Creative Commons Attribution (CC BY) license (https://creativecommons.org/licenses/by/4.0/).
Share and Cite
Zhao, H.; Song, Z.; Liu, X.; Gong, S.; Tang, Q.; Liu, C.; Zhang, Y.; Zhang, X.; Gao, H.; Gao, W.; et al. Functional Characterization of Squalene Epoxidases from Siraitia grosvenorii. Plants 2025, 14, 1740. https://doi.org/10.3390/plants14121740
Zhao H, Song Z, Liu X, Gong S, Tang Q, Liu C, Zhang Y, Zhang X, Gao H, Gao W, et al. Functional Characterization of Squalene Epoxidases from Siraitia grosvenorii. Plants. 2025; 14(12):1740. https://doi.org/10.3390/plants14121740
Chicago/Turabian StyleZhao, Huan, Ze Song, Xuan Liu, Shukun Gong, Qi Tang, Changli Liu, Yifeng Zhang, Xianan Zhang, Haiyun Gao, Wei Gao, and et al. 2025. "Functional Characterization of Squalene Epoxidases from Siraitia grosvenorii" Plants 14, no. 12: 1740. https://doi.org/10.3390/plants14121740
APA StyleZhao, H., Song, Z., Liu, X., Gong, S., Tang, Q., Liu, C., Zhang, Y., Zhang, X., Gao, H., Gao, W., Hu, Y., & Huang, L. (2025). Functional Characterization of Squalene Epoxidases from Siraitia grosvenorii. Plants, 14(12), 1740. https://doi.org/10.3390/plants14121740

